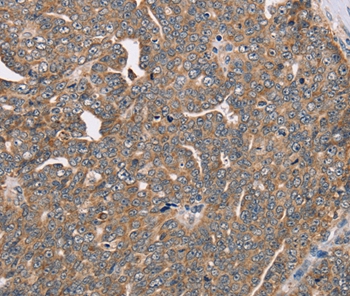
Anti-FAIM2 Antibody

FAIM2 Antibody - N-terminal region (OASG02633)
OASG02633
ApplicationsWestern Blot
Product group Antibodies
TargetFAIM2
Overview
- SupplierAviva Systems Biology
- Product NameFAIM2 Antibody - N-terminal region (OASG02633)
- Delivery Days Customer23
- ApplicationsWestern Blot
- CertificationResearch Use Only
- ClonalityPolyclonal
- Concentration1 mg/ml
- FormatLiquid. 1 mg/mL in PBS containing 50% glycerol, 0.5% BSA and 0.02% sodium azide.
- Gene ID23017
- Target nameFAIM2
- Target descriptionFas apoptotic inhibitory molecule 2
- Target synonymsLFG, LFG2, NGP35, NMP35, TMBIM2, protein lifeguard 2, neural membrane protein 35, transmembrane BAX inhibitor motif-containing protein 2
- HostRabbit
- IsotypeIgG
- Storage Instruction-20°C
- UNSPSC12352203